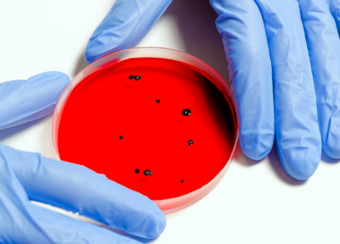

Oggi più che mai, in vista delle future missioni di esplorazione spaziale con equipaggio, quello della protezione planetaria è un tema caldo, sul quale il Comitato per la ricerca spaziale (Cospar), insieme alle principali agenzie spaziali del mondo, sta ampiamente discutendo per cercare di rivederne le linee guida, basate sulle indicazioni risalenti a oltre 50 anni del “Trattato sullo Spazio esterno”.
L’obiettivo è quello di arrivare a nuove raccomandazioni più stringenti, volte a preservare i futuri mondi da esplorare evitandone la contaminazione interplanetaria – tanto quella di ritorno, causata dall’introduzione di eventuali organismi extraterrestri sulla Terra, quanto quella diretta, causata invece dal trasferimento di forme di vita terrestri su un altro corpo celeste. Caso, quest’ultimo, non certo impossibile. Basti considerare che i batteri, semplici organismi unicellulari, sono presenti dovunque, su qualsiasi superficie – a partire ovviamente dalla nostra pelle, colonizzata da miliardi di germi, la maggior parte dei quali innocui in condizioni normali. Data l’enorme potenziale di adattabilità di questi organismi, ipotizzare che possano sopravvivere ai viaggi nello spazio e adattarsi a un ambiente extraterrestre non è da escludere.
In uno studio condotto nel laboratori del Radboud University Medical Center, i cui risultati sono pubblicati sulla rivista Astrobiology, un team di ricercatori guidato da Jorge Domínguez-Andrés, postdoc presso l’Institute for Molecular Life Sciences, ha valutato in vitro e in vivo proprio questo aspetto: la capacità di alcune specie batteriche di sopravvivere quando sottoposte a un “regime alimentare alieno”, e la loro eventuale capacità di adattarsi.
Il team ha selezionato, in particolare, quattro specie di batteri: Serratia marcescens, Burkholderia cepacia, Klebsiella pneumoniae e Pseudomonas aeruginosa – tutti patogeni opportunisti, cioè microrganismi che non sono in grado di causare malattia in individui sani, ma che possono diventarlo approfittando di un abbassamento delle difese immunitarie.

Effetti che si verificano nei batteri patogeni ambientali cresciuti usando fonti carbonacee extraterrestri e le loro conseguenze sulla l’immunogenicità. Crediti: Jorge Domínguez-Andrés et al., Astrobiology 2020
I microscopici organismi, una volta seminati su apposite piastre di coltura, sono stati sottoposti a una “dieta” attraverso l’aggiunta di terreni di coltura contenenti elementi essenziali per la loro crescita: azoto inorganico (ione ammonio), fosforo (fosfato), zolfo (solfato), ferro, acqua e – qui veniamo al dunque – come unica fonte di carbonio, zuccheri isolati da meteoriti carbonacee, come la meteorite di Murchison, per valutarne, come detto, la capacità di sopravvivenza in un ambiente extra-terrestre. Ebbene, il risultato di questi esperimenti in vitro ha mostrato che le specie batteriche in questione sono in grado non solo di sopravvivere ma anche di moltiplicarsi.
Esperimenti in vivo effettuati su topi hanno inoltre evidenziato altro: questi batteri, soprattutto Klebsiella pneumoniae, andavano incontro a una sorta di adattamento, causato dai cambiamenti nella loro parete cellulare, l’involucro esterno di questi organismi. Cambiamenti a seguito dei quali il sistema immunitario dell’organismo ospite – in questo caso, dei topini infettati – reagiva scatenando una risposta immunitaria più forte. I batteri diventavano cioè più immunogeni, sebbene, per via della particolare dieta seguita, fossero meno virulenti rispetto ai loro simili sottoposti a una dieta normale.
Questa ricerca, tramite studi in vitro e in vivo, dimostra dunque che i batteri, almeno le specie in esame, non solo sono capaci di sopravvivere utilizzando come fonte di nutrienti zuccheri “alieni”, ma possono anche adattarsi – modificando, come in questo caso, la loro parete cellulare: il biglietto da visita che il nostro sistema immunitario utilizza per riconoscerli e combatterli. Questo significa che il rischio di infezione tra gli astronauti rimane e va considerato, anche perché, come dimostrato da alcuni studi, un viaggio nello spazio ha effetti negativi sul sistema immunitario, rendendolo più sensibile alle infezioni.
Per saperne di più:
- Leggi su Astrobiology l’articolo “Growth on Carbohydrates from Carbonaceous Meteorites Alters the Immunogenicity of Environment-Derived Bacterial Pathogens” di Jorge Domínguez-Andrés, Marc Eleveld, Georgios Renieris, Thomas J. Boltje, Rob J. Mesman, Laura van Niftrik, Sam J. Moons, Petra Rettberg, Jos W.M. van der Meer, Evangelos J. Giamarellos-Bourboulis, Huub J.M. Op den Camp, Marien I. de Jonge e Mihai G. Netea